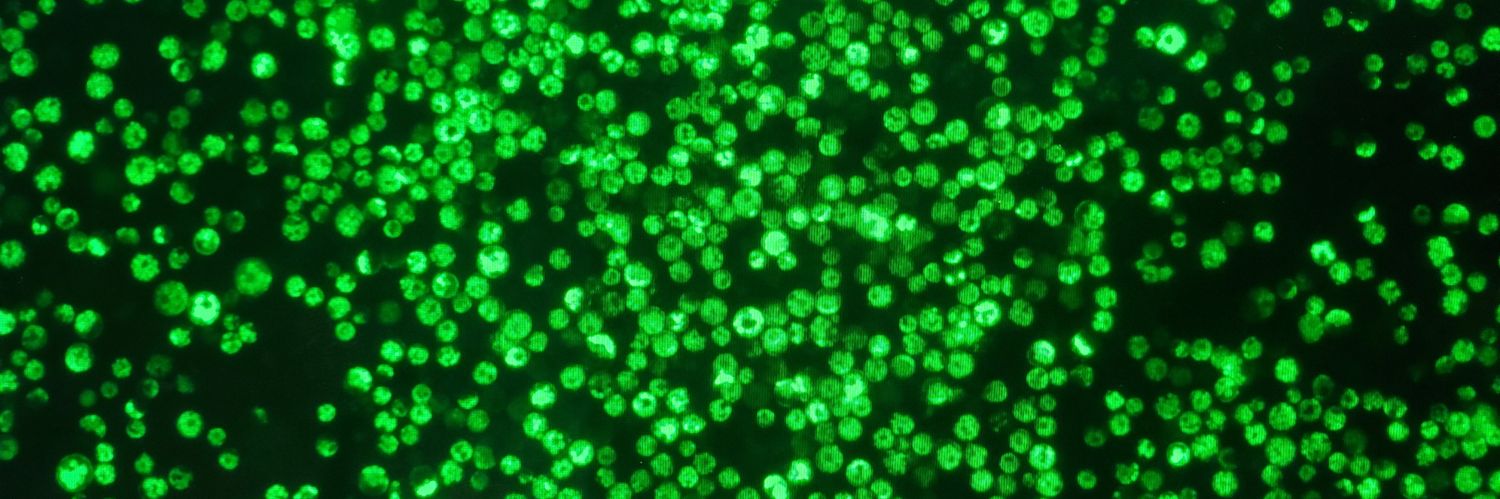
@KarlHvM@scicomm.xyz*️⃣ banner

17.3K posts

@KarlHvM
Dr. Karl Haro von Mogel Ph.D. in Plant Genetics and SciComm, Postdoc at UCR, Director of https://t.co/UqhjljqI1k, & maker of awesome shirts. Tweets = mine




Finger limes appear as a promising choice to growers searching for alternative citrus crops that can thrive in Florida. See how a NIFA-funded @UF_IFAS researcher is working to bring this crop to Florida’s citrus industry. blogs.ifas.ufl.edu/hosdept/2025/0…



I’m a chemist. Let me explain what organic really means. Organic means carbon-based. It includes things like sugar, caffeine, plastic, gasoline and you. So no, organic doesn’t mean safe. It doesn’t mean natural. It doesn’t mean healthy. If it has carbon, it’s organic.


I'll bet you anything JFK had mRNA in his system when he died








Imagine a world without mRNA



